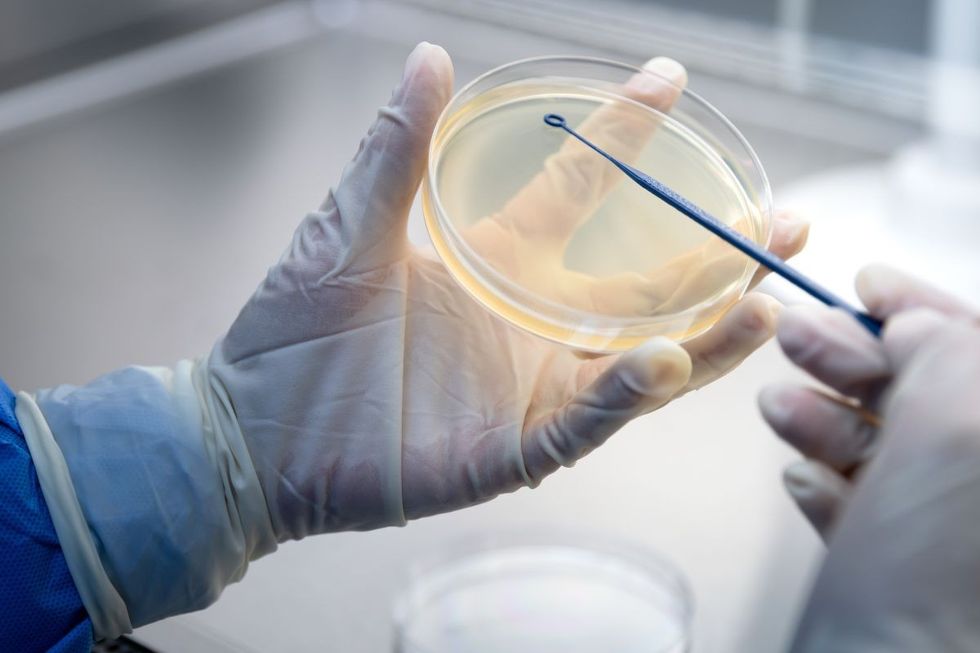
PETRI DISH

'Moves quickly!' Scientists say Covid helped spread of deadly fungus as drug resistance grows

Experts have shared what we know about the deadly fungus so far, and who's at risk
Don't Miss
Most Read
A drug-resistant fungal infection called Candida auris is sweeping through hospitals across the globe, putting some of the most vulnerable patients at serious risk.
Scientists are honing in on the stubborn pathogen after it established itself on multiple continents, with ongoing outbreaks hitting hospitals and long-term care facilities in the UK and beyond.
TRENDING
Stories
Videos
Your Say
The numbers show that more than half of patients who develop invasive infections die despite receiving antifungal treatment, with the risks greatest for patients in intensive care units, those on ventilators, cancer patients, and transplant recipients.
It also appears cases have climbed since the pandemic, partly due to genuine spread and partly because laboratories have become better at spotting it.

The fungus continues to find ways into high-risk wards
|GETTY
Nowadays, most hospitals already have protocols ready to activate when cases emerge, but the fungus continues to find ways into high-risk wards where it can cause harm.
Why is the fungus prevalent in hospitals?
The pathogen colonises skin and can survive for weeks on bedrails, medical equipment, and other hospital surfaces – and it shrugs off many of the standard disinfectants that hospitals typically rely on.
LATEST DEVELOPMENTS
Tobias Mapulanga, a Biomedical Scientist at Repose Healthcare, told GB News: "Transmission happens via hands, shared devices like blood pressure cuffs and thermometers, and patient transfers between wards and facilities, so once it enters a high-acuity setting it can move quickly."
Early detection was hampered because many laboratories initially mistook it for other yeasts, allowing silent spread before anyone realised what they were dealing with.
Pandemic pressures also weakened hand hygiene and environmental cleaning in some facilities, giving the fungus additional opportunities to take hold.
When it comes to treating Candida auris, doctors face a frustratingly narrow set of options.
Mapulanga explained: "We start with echinocandins as first-line therapy because many C. auris strains are resistant to azoles like fluconazole from the outset."
Unfortunately, resistance to echinocandins is now emerging in some clusters, which leaves clinicians with amphotericin B – a drug that comes with serious kidney and infusion-related side effects.
Oral step-down options are limited, and the complex drug interactions plus organ dysfunction common in ICU patients make dosing a real headache.
Mapulanga noted that the high death rate reflects delayed diagnosis, few drug choices, and the underlying frailty of affected patients rather than any single treatment failure.
"It remains treatable, but the margin for error is thin and early, correct therapy plus source control make the biggest difference," he said.
The good news is that the drug pipeline is finally delivering some promising new weapons against resistant strains.
Bailyn Fields, a former registered nurse and health educator at Boomer Benefits, explained: "Rezafungin, a once-weekly echinocandin, is now approved for invasive candidiasis and shows activity against C. auris, which can simplify treatment and outpatient continuation when appropriate."
Another medication called ibrexafungerp, which works as an oral glucan synthase inhibitor, is being developed for invasive disease and has shown activity against the fungus in laboratory testing.
An additional, and perhaps the most promising treatment is Fosmanogepix, a first-in-class drug targeting a new fungal pathway that's currently progressing through clinical trials.
Fields noted that as these treatments become available, combining them with rapid diagnostic testing and careful antibiotic stewardship will be essential to ensure they remain effective long-term.
Hospitals are now deploying a comprehensive bundle of measures to stop the fungus in its tracks.
Fields explained that screening swabs from armpits and groins on admission or after exposure, combined with accurate laboratory identification using MALDI-TOF or PCR technology, allows teams to isolate patients quickly and avoid misidentification.
Candida auris is sweeping through hospitals across the globe
|GETTY
Contact precautions, single rooms or cohorting, dedicated equipment, and daily chlorhexidine bathing for colonised patients all help reduce bedside transmission.
Environmental cleaning has become crucial, with facilities using agents proven to work against Candida auris, such as bleach or hydrogen peroxide products, backed by thorough daily and terminal cleans with audits to check everything's been done properly.
Removing lines and catheters promptly, reinforcing hand hygiene, sending clear alerts when patients transfer between facilities, and notifying public health authorities complete the protective package.
For healthy people, the everyday risk remains low – the real danger lies with hospitalised and immunocompromised individuals.
Our Standards: The GB News Editorial Charter










